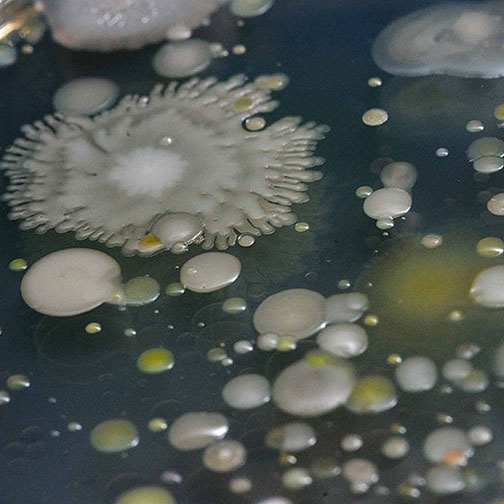
Close-up of a dish containing a rapid biosensor test for foodborne pathogens.

Quick Links
- Applied Engineering Sciences
- Biomedical Engineering
- Biosystems and Agricultural Engineering
- Chemical Engineering and Materials Science
- Civil and Environmental Engineering
- Computational Mathematics, Science and Engineering
- Computer Science and Engineering
- Electrical and Computer Engineering
- Mechanical Engineering
- Technology Engineering

Applied Engineering Sciences
Applied Engineering Sciences (AES) at Michigan State University is a unique interdisciplinary program that combines the technical strengths of engineering with the savvy expertise of business. The resulting blend creates technically sound and business-bound graduates who are ready to tackle the complex problems of an ever-changing world.

Biomedical Engineering
Biomedical Engineering (BME) at Michigan State University engages faculty across disciplines, departments, and colleges to explore the intersection of medicine, human biology, and engineering research, design, and practice. BME’s goal is to develop new methods for understanding, diagnosing, and treating medical conditions, and translating discoveries from the laboratory to the classroom and the clinic.
Biosystems and Agricultural Engineering
Programs offered by the Department of Biosystems and Agricultural Engineering are jointly administered by the College of Agriculture and Natural Resources and the College of Engineering. Since 1906, the Department of Biosystems and Agricultural Engineering (BAE) has responded to the changing needs of society by integrating and applying principles of engineering and biology in a systems context. Today, biosystems engineers at MSU solve complex, rapidly changing problems related to food quality and safety, ecosystems protection, homeland security and health protection, biomass utilization, and renewable energy development.

Chemical Engineering and Materials Science
Chemical Engineering and Materials Science (ChEMS) offers two excellent degree programs to transform Spartans into innovative engineers with a foundation of mathematics, physics, chemistry, life sciences, and engineering science. Students have access to outstanding laboratories for biochemical engineering, composite materials processing, and characterization of metals, ceramics, and polymers. New opportunities abound in microelectronics, biomaterials, environmentally friendly materials, and nanotechnology.

Civil and Environmental Engineering
The Department of Civil and Environmental Engineering (CEE) at MSU offers undergraduate and graduate degrees using a robust design-build education. This high-quality experience is a perfect blend of theory and application. High-achieving students have opportunities for undergraduate research and pursuit of the shared B.S. - M.S. programs in civil engineering or environmental engineering.

Computational Mathematics, Science and Engineering
The Department of Computational Mathematics, Science and Engineering is jointly administered by the College of Natural Science and the College of Engineering. The Department of Computational Mathematics, Science and Engineering (CMSE) is focused on applications that are aligned with experimental expertise at MSU and targets applications in the physical, biological, and engineering sciences. CMSE faculty members focus on the science of algorithm development – an area that is key to many application core areas in science.

Computer Science and Engineering
It’s an exciting time to be a computer scientist. The Department of Computer Science and Engineering (CSE) is now the largest academic unit in the College of Engineering and one of the largest at MSU. It’s because modern life is full of connected, computational devices, so CSE offers a tailored blend of fundamental learning, cutting-edge technologies and 20 laboratories with 21st Century research strengths.

Electrical and Computer Engineering
The Department of Electrical and Computer Engineering (ECE) has a tradition of excellence in teaching and research that dates to 1909. An ECE degree prepares electrical and computer engineers for a dynamic, ever-changing field and offers an excellent background in medicine, law, business, and other analytical disciplines. Our faculty are actively engaged in electromagnetics, materials and devices, microelectronics, computing, robotics and control, energy and power systems, signal processing and communications.

Mechanical Engineering
Mechanical Engineering (ME) is one of the oldest academic disciplines at Michigan State University and continues to fulfill its forward-thinking role through the fundamental principles of mechanics, thermosciences, and design. Leading-edge research and pioneering studies help talented students pursue their diverse interests in aerospace, automotive and manufacturing, robotics, medical devices and artificial organs, and renewable energy.

Technology Engineering
Technology Engineering (TechE) is a pioneering, multidisciplinary initiative that integrates mechanical, electrical, and computer engineering with computer science to offer an innovative educational experience. Program courses cover a range of topics including mechatronics, hardware cybersecurity, electronics, embedded systems, automation, data science, and computer hardware/software development. Through hands-on, real-world projects, students integrate modern technologies with a foundational engineering mindset.






